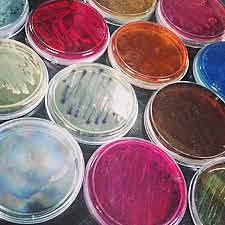
Pasteur

-
Denominaban a los microorganismos "seres invisibles" y eran directamente asociados con la brujería.
-
Propone que algunas formas de vida, se crean de manera espontanea, por ejemplo las larvas o las moscas, propuesta por Aristoteles en la antigua Grecia
-
Apoya la hipótesis de las criaturas invisibles y creía que podían causar enfermedades.
-
Aplica el concepto de Bacon a la transmisión de la sífilis.
-
Contradice la teoría de la generación espontánea, gracias a un experimento que hizo con unas larvas provenientes de huevos de mosquitos.
-
Inventa el primer microscopio y a las bacterias observadas las llama "animaliculos"
-
realizó varios experimentos para desmentir la generación espontaneas; estos consistían en hervir trozos de carne y descubre colonias de microorganismos destruidas por esto. (Esto y gran parte de lo anterior fue basado de:
http://webcd.usal.es/Web/educativo/micro2/tema01.html) -
Repite el experimento de Jphn Needham, pero tapa los recipientes en los que esta la carne, por lo que no aparecen colonias.
-
Edward Jenner vacunó por primera vez y de forma exitosa a un niño con viruela.
-
Realiza trabajos con la fermentacion de algunas bacterias y la conservación de alimentos tales como el vino.
-
Este cirujano logra probar que los microorgnismos forman algunas enfermedades humanas y mejora la cirugía antiséptica.
-
Descubre que las bacterias son causantes de enfermedades sobretodo infecciosas.
-
Cultiva la bacteria que causa el cólera en las gallinas para aislarla.
-
Descubre la vacuna contra la rabia
-
Utiliza por primera vez la palabra virus, y descubre uno que afectaba el tabaco
-
Este microbiologo descubre la penicilina (inicio de los antibióticos)
-
Descubre un colorante que impide el crecimiento de bacterias dentro del cuerpo llamado sulfamida (inicio de la quimioterapia).
-
Descubrieron la estructura molecular del ADN.
Tomado de:
https://www.saberdeciencias.com/apuntes-de-microbiologia/140-microbiologia-breve-historia -
Oswald Avery, Colin Macleod y Maclyn McCarthy descubren el papel del ADN en la genética bacteriana. tomado de:
http://www.argenbio.org/index.php?action=novedades¬e=140 -
Descubrimiento de viroides en las plantas.
-
Logran producir anticuerpos monoclonales gracias a hibridomas.
-
Descubre los priones, una especie infecciosa que causa enfermedades en el sistema nervioso.
Looking for a timeline maker?
Create timelines for projects, roadmaps, history, lessons, legal cases, and stories with Timetoast. Timetoast is a timeline maker for work, school, research, and stories.